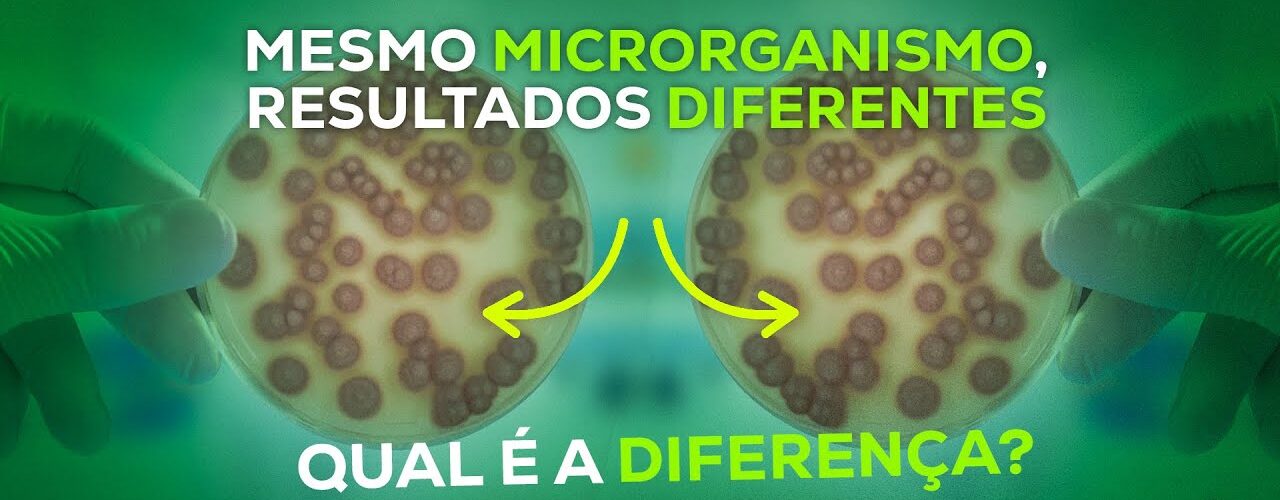

No contexto da agricultura, cepas (ou estirpes) são variantes genéticas de um mesmo microrganismo (como bactérias, fungos ou vírus). Imagine que a espécie é a “família” e a cepa é o “indivíduo” com talentos específicos.
Embora pertençam à mesma espécie, duas cepas podem ter comportamentos completamente opostos no campo: uma pode ser altamente eficiente em fixar nitrogênio, enquanto a outra é apenas “comum”.
O que diferencia uma Cepa de outra?
A diferença está no DNA. Pequenas variações genéticas conferem habilidades especiais a certas cepas, como:
- Resistência ambiental: Capacidade de sobreviver em solos muito secos, ácidos ou com altas temperaturas.
- Competitividade: A habilidade de “ganhar a briga” contra microrganismos nativos do solo e colonizar a raiz da planta.
- Produção de enzimas: Algumas cepas produzem mais fitormônios (que fazem a planta crescer) ou antibióticos naturais (que matam pragas).
Impactos no Resultado do Campo
A escolha da cepa correta dentro de um inoculante ou biodefensivo é o que define o sucesso da safra. Veja como isso impacta a prática:
1. Fixação Biológica de Nitrogênio (FBN)
Na soja, por exemplo, usamos o Bradyrhizobium. Existem centenas de cepas dessa bactéria na natureza, mas apenas algumas (como a CPAC 15 ou Semia 5079) são selecionadas em laboratório por sua capacidade extrema de converter o nitrogênio do ar em alimento para a planta.
- Impacto: Usar a cepa errada pode resultar em uma planta amarelada e com baixa produtividade, mesmo que haja bactérias no solo.
2. Controle Biológico (Pragas e Doenças)
No caso do fungo Beauveria bassiana (usado contra cigarrinha e percevejo), a cepa faz toda a diferença. Algumas cepas são mais agressivas contra um inseto específico e menos contra outros.
- Impacto: Uma cepa específica para o milho pode não ter a mesma aderência na cutícula de uma praga que ataca o café.
3. Solubilização de Fósforo
Existem bactérias que “derretem” o fósforo que está preso na terra para que a planta consiga beber. Cepas de elite conseguem liberar muito mais fósforo do que cepas selvagens.
- Impacto: Maior desenvolvimento radicular e economia de fertilizantes químicos caros.
Tabela Comparativa: Cepa “Comum” vs. Cepa “Elite”
| Característica | Cepa Nativa (Selvagem) | Cepa Elite (Laboratório) |
| Colonização | Lenta e instável | Rápida e agressiva |
| Fixação de Nutrientes | Baixa a moderada | Máxima eficiência comprovada |
| Resistência a Seca | Baixa | Selecionada para tolerar estresse |
| Produtividade Final | Padrão do solo | Incremento real de sacas/ha |
O que o produtor deve observar?
Ao comprar produtos biológicos ou inoculantes, não olhe apenas para o nome da espécie (ex: Bacillus subtilis). Verifique qual é a identificação da cepa (ex: Bacillus subtilis cepa QST 713).
É essa codificação que garante que você está colocando no campo um microrganismo “atleta de alta performance” e não apenas uma bactéria comum que não trará retorno sobre o investimento.
Adicionar Comentários